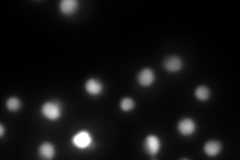
YOR230W

View description
Transcriptional modulator involved in regulation of meiosis, silencing, and expression of RNR genes; required for nuclear localization of the ribonucleotide reductase small subunit Rnr2p and Rnr4p; contains WD repeats
Localization:
Intensity:
Fold change:
Significance:
-
C’ GFP library in SD

nucleus110.42 -
N' NOP1pr-GFP in SD

nucleus,nucleolus359.646 -
N' TEF2pr-mCherry in SD
nucleus424.41 -
N' NATIVEpr-GFP in SD

punctate,nucleus117.201 -
N' TEF2pr-VC and Cyto-VN in SD

#N/A0 -
C’ GFP library in SD+DTT

punctate161.261.46Yes -
C’ GFP library in SD+H2O2

nucleus152.91.38Yes -
C’ GFP library in Starvation Media

punctateN/AN/AYes -
C’ GFP library on the background of Pup2-DaMP

punctate -
C’ GFP library on the background of CCT mutant

nucleus109.3110.989908No
